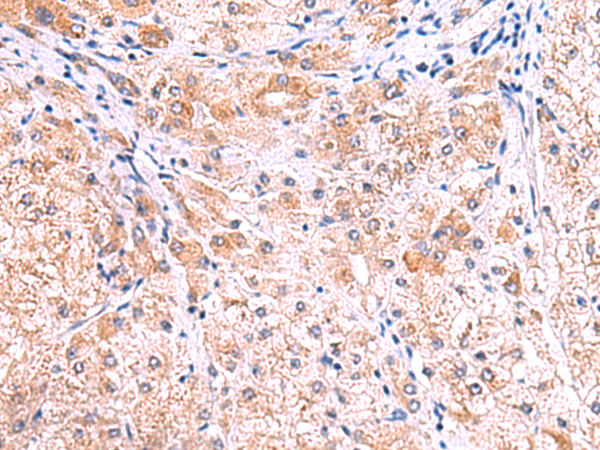
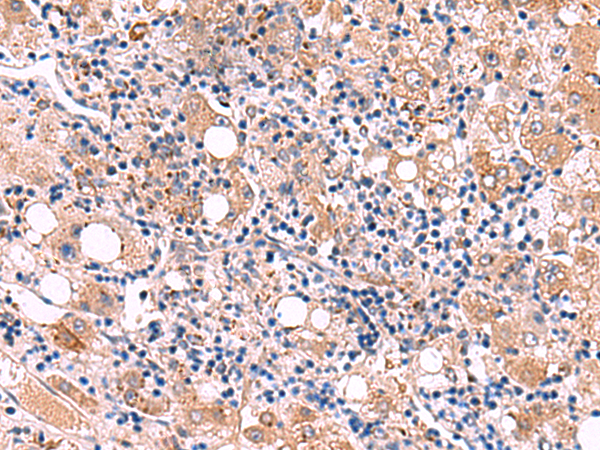
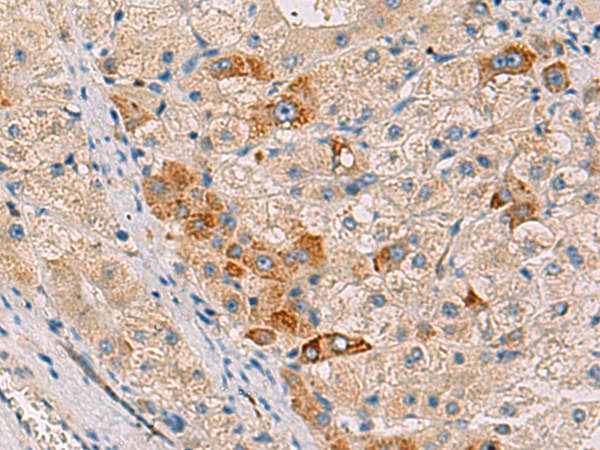

-
分类: 科研抗体货号: P03036别名: p27; SSSCA1应用: WB,IHC反应种属: Human, Mouse
-
分类: 科研抗体货号: P03150别名: ISC1; NSMASE; NSMASE1应用: WB,IHC反应种属: Human, Mouse, Rat
-
分类: 科研抗体货号: P03147别名: UGD; SDR6E1应用: IHC反应种属: Human, Mouse, Rat
-
分类: 科研抗体货号: P03109别名: GPD1-L应用: IHC反应种属: Human, Mouse
-
分类: 科研抗体货号: P03140别名: LAL; CESD应用: IHC反应种属: Human
-
分类: 科研抗体货号: P03107别名: LRG; HMFT1766应用: WB,IHC反应种属: Human, Mouse
-
分类: 科研抗体货号: P03139别名: ESET; KG1T; KMT1E; TDRD21; H3-K9-HMTase4应用: IHC反应种属: Human, Mouse
-
分类: 科研抗体货号: P03106别名: DRC10; CFAP84; 4933433C09Rik应用: WB,IHC反应种属: Human, Mouse
-
分类: 科研抗体货号: P03138别名: RMD2; RMD4; RMD-2; FAM82A; BLOCK18; FAM82A1; PRO34163; PYST9371应用: WB,IHC反应种属: Human, Mouse, Rat
-
分类: 科研抗体货号: P03105别名: SPG33; PROTRUDIN应用: WB,IHC反应种属: Human, Mouse, Rat

鄂公网安备42018502007531号
鄂公网安备42018502007531号

